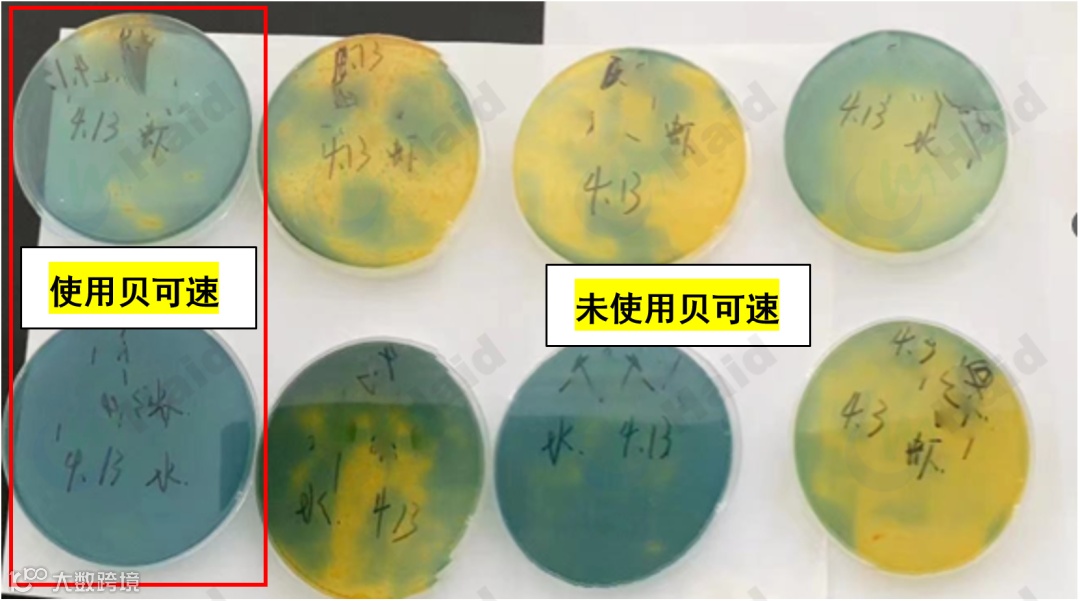

文 | 图 浙江海大 刘 超
养殖82天,规格28头,单棚产量1800斤、棚效益46800元;海兴农小棚苗+浙江海大功能料+海联科保健料,拉虾成活率97%!
小棚模式扎根山东东营一年有余,如果说2021年是东营小棚的元年,那么2022年便是腾飞的一年,实践证明东营小棚养殖是成功的。
坐标:山东东营汀罗园区诸葛老板
饲料:贝可速+虾多康+加餐宝
苗种:海兴农小棚苗
放苗时间:3月16日
评价:养殖82天,规格28头,26元/斤,单棚产量1800斤、棚效益46800元;海兴农小棚苗+浙江海大功能料+海联科保健料,长势快、体色好、活力一级棒,拉虾成活率97%,客户满意,近期持续出虾。
【优质小棚料,浙江海大造!】
相较于2021年,今年养殖节奏趋于正常,2022年东营汀罗养殖园区首批放苗客户放苗时间在3月13日-3月16日,目前已陆续出虾。
东营3、4月份的天,如孩子的脸、说变就变,在这种情况下,我们的客户做到养殖82天、规格28头、棚产1800斤、棚效益46800元!成功的秘诀是什么呢?
今天就和大家一起走进山东小棚,聊聊浙江海大对山东小棚的理解。
从江苏盐城东台的弶港镇,驱车到山东东营汀罗养殖园区,全程700公里,基本是一路向北。山东的温度要显著低于江苏,所以在养殖规划上也要重新梳理。



追踪近3年气温的变化发现,4月-11月气温差异性不大;结合之前小棚养殖情况,3月底至4月初,棚内水温即可达到18℃,养殖周期规划在4月至11月上旬较为适宜,养殖周期7.5月,较江苏少2.5个月。
养虾先养水,养水先养底,好的水质及土质,是养殖成功的必备条件。东营作为退海之地,卤水资源丰富;东营,亦是黄河入海之地,黄河水资源充足。

从检测结果看,水质良好,满足南美白对虾生长所需,这对小棚养殖非常有利。

东营本地为退海之地,土质以壤质和沙质土壤为主,土质颗粒适中,符合小棚养殖需求,结合浙江海大养殖管理模式,养殖过程更为顺利。
养殖业是一个系统的行业,天时、地利及人和缺一不可,东营地理位置优越,北靠京津唐经济区,南连山东半岛蓝色经济区,向西辐射广大内陆地区,是环渤海经济区的重要节点、山东半岛城市群的重要组成部分,处于连接中原经济区与东北经济区、京津唐经济区与胶东半岛经济区的枢纽位置,南美白对虾市场需求量大,无论是活虾还是冰虾,价格优势都比较明显。

由上面折线图可以看出:5月29日至6月10日,30头与40头虾对比,每斤虾相差3-5元;由此得知虾早上市,效益明显,因而春虾要快大。
北方冷链业相对发达,对冰虾需求量大,各个规格的虾都有需求,小到200头,大到20头,都有客户群体,市场相当广阔。从前三年的数据来看,相同规格的冰虾与活虾价格,每斤相差0.5-1元,较之南方,价格优势明显。

山东区域养殖模式多样,主要有小棚模式、土塘模式和工厂化模式,小棚模式根据既定“春虾快大、秋虾高产”模式,有效避开了外塘及工厂化的出虾高峰期,达到错峰上市,填补了6月下旬至7月初、10月底到11月初本土市场的空缺。
针对山东小棚现状,浙江海大技术服务团队,整合各方资源,为解决养殖2季虾的问题,提出“春虾快大,秋虾高产”模式。
春虾3月底-4月初放苗,6月底出虾;秋虾,7月上旬放苗,11月初出虾;养殖周期7.5个月,核心产品组合:PL20苗+贝可速+虾多康+加红料+加餐宝。

东营小棚已发展一年有余,结合一年两季模式,苗种选择显得尤其重要,经过2造虾的实践证明,海兴农小棚苗是目前山东小棚客户的首选。

统计了2021年汀罗园区17位老板的养殖数据,平均养殖天数87天,规格达到28头,苗种表现优异;其中养殖周期最快75天,虾规格27头。
今年放苗时间平均较去年提前1个多月时间,最早的一批在3月13-16日,前期温差大、余氯反弹等情况都有发生,这对苗种成活率带来了一定的影响。
因此,苗期强免疫、保存活尤为重要,应对此类情况,浙江海大服务团队有办法!
①水质检测
放苗前对每个客户做水质指标检测,指标合格后,试水成功率95%以上再放苗。
苗期20天,对园区80位客户,进行5轮余氯检测,共400人次,发现余氯反弹0例,目前无一例因余氯问题出现爆塘情况。

②好苗料,强营养
高端苗料贝可速,富含优质蛋白、中草药及其它强免疫因子,配合低温制粒,对虾的肝胰腺发育、稳定水质及抑制弧菌等方面效果明显。
同时期放的苗,10天后,使用贝可速的苗体色靓,整齐度好、规格大,肝胰腺发育好、有弹性,白膜轮廓清晰。


放苗1周时间,取了4位客户的虾样及水样,做弧菌检测;我们可以清晰看到,使用贝可速的样品(含水样、虾样)检出弧菌量,明显少于使用粉料的样品(红色方框内为使用贝可样品的检测结果)。
经过一年的深耕细作,我们对东营小棚养殖,特制定独有的饲料主线方案:贝可速+虾多康(破碎、颗粒)+加餐宝。实践证明,本方案是完全符合养殖需求的。

诸葛老板使用本方案后的效果呈现:
诸葛老板3月16日放苗,海兴农PL10,全程使用贝可速+虾多康,养殖41天,打样80头;后改4餐投喂,养殖67天,打样39头。养殖76天,打样28头,后9天平均1天长1头,日增重0.56g,长势迅猛,拉虾成活率高,体色靓。

卖虾瞬间:
①肠炎、慢料
随着气温的不断升高,水温也逐渐起来,肠炎、慢料情况日益显现。
汀罗园区张老板,38张棚,3月5日投苗5万/棚,5月12日,2号棚出现慢料情况,110分钟查料台未吃完;加餐宝添加10%拌喂,每日3餐,3天后效果明显,吃料正常、加料顺畅。


加餐宝,除了预防轻微肠炎、改善慢料外,对虾吃料提速效果也较为明显。
下图为额外添加10%加餐宝与未添加组做的对比,添加加餐宝的棚主虾吃料时间快10min,即添加加餐宝可额外多加料。

➣使用方案:
a.正常投喂:10%额外添加投喂;
b.轻微肠炎、慢料:20%-50%替代干料拌喂,连续2天;
c.严重肠炎:加餐宝+健多宝,比例为1:1,替代干料投喂1餐/天,连续投喂3天。
②肥水难
放苗早期,水体中有机质少,水温偏低、藻类丰度小,肥水困难,该怎样改善呢?
汀罗园区刘老板,4月7日放海兴农小棚苗,密度5.5万,5月1日反映水开始转浑,氨氮、亚盐飙升,氨氮达到1.5,亚盐3;水色黄浑,水面藻泡少,镜检藻类多为死藻,藻类丰度低。
使用我司肥水方案,连续使用2天,水面藻泡多、镜检藻类丰度高,以硅藻为主,水质指标趋于正常,虾子吃料正常,客户非常满意。

➣使用方案(1张棚):
菌藻旺(4斤)+育藻膏(1斤)+养水精华(2斤)+钙镁佳(1斤)。
【小 结】
东营小棚经历了一年的积淀,技术趋于成熟,目前发展势头迅猛;在高速发展的同时,我们要思考所匹配养殖规划、产品及服务是否到位。
汀罗园区作为山东第一个规模化小棚养殖园区,初始定位即是高标准、严要求。从始至终,秉承苗、料及动保协同发展的宗旨,从春虾开始到秋虾结束,我们浙江海大服务团队在各个环节都有周密规划,结合养户的精湛技术,从养成到高产的路会越走越顺,坚信东营小棚的发展会更上一个台阶!
海大农牧
接地气的水产一线技术
长摁二维码,即刻关注





